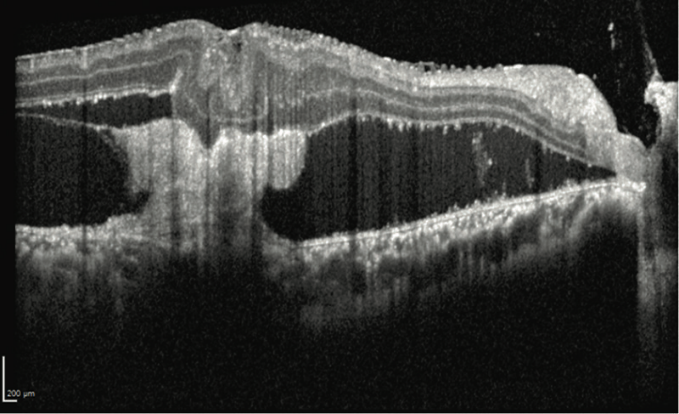

编者按:眼后段外伤的性质多变,解剖位置不定,术中易出血,术后易出现增生性玻璃体视网膜病变等并发症,对眼后段外伤的处理令人闻之却步。近期Yewlin Chee教授分享了两例眼外伤后的视网膜并发症的处理,她认为虽然每个外伤性病例都是独一无二的,但一套标准的步骤和原则可以辅助眼科医生完成挑战性的视网膜脱离修复。
病例报告一
患者为老年男性,右眼III区眼球破裂伤,破裂口自外直肌止点呈放射状向后延伸10mm。患者的眼球破裂伤已于一期缝合,术中外直肌被切断并重新缝合。术后复查,眼部B超提示术眼存在累及颞侧黄斑区的视网膜脱离。Yewlin Chee教授团队对该患者进行了二期玻璃体切除手术,具体流程如下:
1.脉络膜上腔引流:在尝试引流前,应通过B超确认大出血性脉络膜脱离已液化。
2.放置巩膜扣带:如果在一期缝合时曾断开眼直肌,巩膜扣带的放置可能会很困难,本例中先对瘢痕组织进行分离松解,后行巩膜扣带术;值得注意的是,若对视网膜行360°切开,则可不需巩膜扣带。
3.晶状体摘除:晶状体摘除可提高术中可视性,使术者能够完整地切除前部玻璃体。
4. 剥离视网膜前膜:基于术前B超影像,从鼻上方开始切除玻璃体,找到视网膜和视盘,剥离视网膜前膜。
5.识别并释放嵌顿部位:视网膜嵌顿在巩膜伤口内,术者使用剪刀和玻璃体切割机完成视网膜切除术,并释放嵌顿的视网膜组织。
6.压平视网膜:在较大的视网膜切除术中,通常使用重水压平视网膜。对于该病例,术者认为视网膜切除后,气液交换足以排出视网膜下积液。
7.视网膜激光:在切开的视网膜边缘打两到三排激光(见图1)。
8.填充硅油。

图1. 在切开的视网膜边缘打两到三排激光
Yewlin Chee教授指出,对于本病例术前需要考虑的相关因素包括:受伤的分区;伤口位置、轨迹和长度;肌肉是否被切断。此外,进行详细的术前B超对识别出血性脉络膜脱离、视网膜脱离的位置、后部玻璃体的状态至关重要。
病例报告二
患者为24岁男性,3个月前头部及眼眶多处枪伤,左眼视力无光感,视网膜完全脱离,与晶状体后囊粘连,无法手术;右眼视力20/150。眼前节检查正常;散瞳后检查眼底显示后极部广泛瘢痕,可见视网膜前膜和视网膜下膜(见图2);OCT提示黄斑区视网膜脱离(见图3)。

图2. 左眼后极部广泛瘢痕,可见视网膜前膜和视网膜下膜,与巩膜损伤一致
图3. 右眼OCT提示黄斑区视网膜脱离
Yewlin Chee教授团队对该患者进行了右眼玻璃体切除手术,考虑到患者仅剩右眼有视力,手术使用了25G玻切头。术中,术者通过眼球内注射吲哚菁绿颜料对内界膜染色,更好的辨别视网膜前膜所在平面。向后延伸穿过视网膜进入视网膜下空间的区域,术者使用眼内剪刀在视网膜表面剪断膜,以减少全层破裂的风险。手术保持了视网膜下膜的完整,避免牵引带来的进一步视网膜脱离以及感光细胞的损伤。术后一个月,OCT示视网膜已经复位(见图4),患者右眼视力稳定在20/100。

图4. 一个月后,右眼OCT示视网膜前膜已剥除,视网膜贴平,视力稳定在20/100
本病例为弹伤性脉络膜视网膜炎引发的牵引性视网膜脱离,弹伤性脉络膜视网膜炎是视网膜和脉络膜的全层损伤,可能穿越整个视网膜,必须谨慎剥离。术前需对OCT仔细读片,确认位置并制定手术计划。值得注意的是,在弹伤性脉络膜视网膜炎的瘢痕边缘可能出现裂孔,导致孔源性视网膜脱离。
小 结
眼球破裂伤若已行一期缝合,二期手术时需仔细核对一期缝合的细节。对于较大的视网膜切除术,重水有助于压平视网膜;然而在某些情况下,气液交换足以排出视网膜下积液。弹伤性脉络膜视网膜炎是视网膜和脉络膜的全层损伤,必须警惕膜通常会横跨整个视网膜,剥离时要谨慎。
2 comments
条评论
Linda Gareth
2015年3月6日, 下午2:51Donec ipsum diam, pretium maecenas mollis dapibus risus. Nullam tindun pulvinar at interdum eget, suscipit eget felis. Pellentesque est faucibus tincidunt risus id interdum primis orci cubilla gravida.